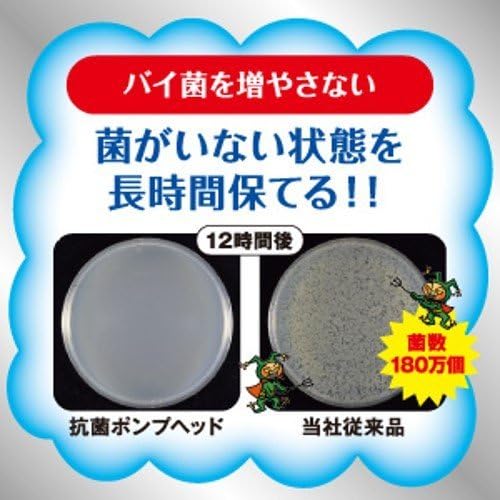

Price: ¥3,157 - ¥3,155
(as of Feb 23, 2021 11:30:22 UTC – Details)

! 液体で出てくるタイプではありません。他の製品につめかえても泡になりません。高温、直射日光を避けて保管してください。飲み物ではありません。◇湿疹、皮ふ炎(かぶれ、ただれ)等の皮ふ障害があるときには、悪化させるおそれがあるので使わない。◇使用中、かぶれたり、刺激を感じたときには使用を中止し、商品を持参し医師に相談する。◇目に入ったときは、すぐに洗い流す。◇乳幼児の手の届くところに置かない。◇大理石の洗面台などで使用するとツヤを失うことがあるので、本品がついたところは、すぐに洗い流す。◇衛生的にご利用いただくために、つめかえる前にポンプボトルの中を水道水で洗い、よく乾かしてください。ポンプ内部は、水が入ると泡にならない場合があるので、ポンプを押さずに洗い、よく乾かしてください。◇中身をつめかえた後、製造番号を記録しておいてください。(製品についてお問合せの際は、この番号をお知らせください。)
「泡で出る」のでお子様からご年配まで簡単に洗えます。殺菌成分配合。きちんと殺菌し、バイ菌から手肌を守ります。すばやく泡切れ、ぬるつかない洗いあがりです。手に残りにくい「シトラスフルーティ」の香りが楽しめます。
付属品:注ぎ口付き
Volume: 1.1 gal (4 L)
Product Size (W x D x H): 8.1 x 4.9 x 10.0 inches (204 x 125 x 252 mm)
Ingredients: Active ingredients: isopropyl methylphenol, other ingredients: PG, sorbit liquid, lauric acid, acylglycine K liquid in coconut oil fatty acid potassium hydroxide, monoethanolamine, lauryl dimethylamine oxide liquid, fragrance, dimethyldiaryl ammonium, acrylamide copolymer liquid, EDTA, polystyrene ethylmethyl ethylmethyl ethylmethyl ethylmethyl ethylmethyl ethylmethyl ethylmethyl ethylmethyl ethylmethyl ethylmethylene ethylmethylene emulsion liquid. , benzoic acid salt, red 401



レビュー
レビューはまだありません。